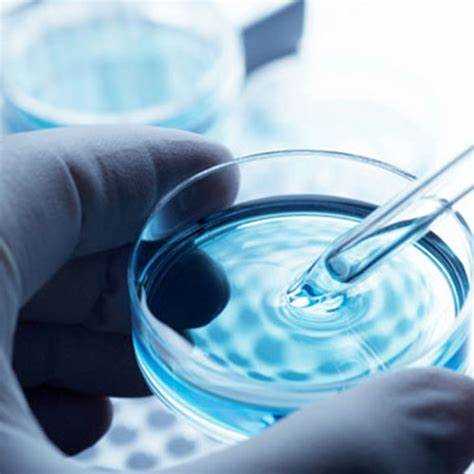

Качество водопроводной и колодезной воды в Москве не всегда соответствует нормативам. Чтобы получить точные данные о составе воды, требуется лабораторный анализ. Сдать пробы можно в аккредитованных учреждениях, расположенных в разных районах города.
В Москве работает несколько десятков лабораторий, принимающих образцы от частных лиц и организаций. Среди них: ФБУЗ «Центр гигиены и эпидемиологии», филиалы «Мосводоканала», частные лаборатории вроде «Инвитро», «Гемотест», «ЭкоТест». Условия приема различаются: где-то требуется предварительная запись, в других местах возможен выезд специалиста на дом.
Стоимость анализа зависит от объема исследования. Базовый санитарно-химический анализ воды обойдется от 1500 до 3000 рублей. Расширенные пакеты с исследованием на тяжелые металлы, нефтепродукты и пестициды могут стоить от 5000 рублей и выше. Срок готовности результатов – от одного до пяти рабочих дней.
Перед сдачей воды важно уточнить в лаборатории правила отбора проб. В большинстве случаев используется пластиковая тара объемом 1,5–2 литра, которую предварительно промывают и заполняют водой по определенной методике. Некоторые лаборатории предоставляют специальные емкости и инструкции.
Для анализа воды из скважины или колодца желательно выбирать лаборатории, имеющие право проводить исследования по СанПиН 1.2.3685-21. Это гарантирует юридическую значимость результатов, например, при подаче документов в Роспотребнадзор или для судебных разбирательств.
Какие виды анализа воды можно сделать в лабораториях Москвы
Лаборатории Москвы предлагают широкий спектр исследований, позволяющих определить химический, микробиологический и органолептический состав воды. Выбор типа анализа зависит от источника воды и цели проверки.
- Химический анализ: определяет наличие и концентрацию веществ, влияющих на безопасность и вкус воды. Включает измерение показателей:
- жесткость (общая, кальциевая, магниевая);
- содержание железа, марганца, меди, цинка, алюминия;
- аммиака, нитратов, нитритов, фосфатов;
- сухой остаток, хлориды, сульфаты;
- водородный показатель (pH);
- окисляемость, перманганатная окисляемость.
- Микробиологический анализ: необходим при проверке воды из колодцев, скважин, водоемов. Исследуется наличие:
- общих колиформ (ОКБ);
- термотолерантных колиформ (кишечная палочка);
- общей бактериальной обсемененности;
- патогенной микрофлоры (при расширенных тестах).
- Органолептический анализ: позволяет оценить вкус, запах, цветность и мутность воды. Эти показатели важны при проверке соответствия воде санитарным нормам.
- Специализированные тесты: для оценки воды на наличие нефтепродуктов, фенолов, пестицидов, радионуклидов. Обычно заказываются при анализе воды из природных источников рядом с промышленными зонами или дачами.
- Комплексные пакеты: лаборатории предлагают готовые программы анализа: для питьевой воды, из скважины, для аквариумов, бассейнов, отопительных систем. Включают набор показателей, необходимых для конкретной ситуации.
Сколько стоит анализ воды в частных и государственных учреждениях

В государственных лабораториях Москвы базовая проверка питьевой воды из скважины или колодца стоит от 500 до 1500 рублей. Это включает физико-химические параметры: мутность, цветность, запах, железо, жёсткость, нитраты. Бактериологическое исследование – от 800 рублей. Полный санитарно-гигиенический анализ обойдётся в 2000–3500 рублей.
В частных лабораториях стоимость выше. Минимальный набор – от 1500 до 2500 рублей. Расширенные пакеты (до 30 показателей) – от 4000 до 7000 рублей. Бактериология – 1000–2000 рублей отдельно. В цену часто включён выезд специалиста, но при удалённости объекта возможна доплата – от 500 рублей.
Если требуется анализ для Роспотребнадзора, следует уточнить, аккредитована ли лаборатория по ГОСТ ISO/IEC 17025. Это влияет на допустимость результатов в официальных документах.
Для разовой проверки достаточно базового анализа. При строительстве или подключении к водопроводу целесообразно заказывать расширенный пакет.
Как выбрать лабораторию для анализа воды в зависимости от цели
Для контроля питьевой воды обращайтесь в лаборатории с аккредитацией по стандарту ГОСТ Р ИСО/МЭК 17025 и опытом анализа на основные показатели: микробиологию, химический состав, тяжёлые металлы, пестициды. Важно, чтобы в перечне услуг была проверка на санитарно-химические и радиационные параметры.
Если нужна экспертиза воды из скважины или колодца, выбирайте лаборатории с оборудованием для определения концентраций железа, марганца, нитратов и общего минерализата, а также с опытом в гидрохимических исследованиях. Такие лаборатории обычно проводят комплексные исследования вод с учетом местных геологических условий.
Для промышленных или строительных целей подходят специализированные лаборатории, которые могут проверить воду на агрессивность по отношению к трубам, содержание растворённых солей и другие физико-химические параметры, влияющие на технологические процессы и материалы.
При необходимости судебной или юридической экспертизы выбирайте лаборатории, имеющие статус судебных экспертов и обладающие необходимыми протоколами отбора проб и проведения анализа, которые будут признаны в официальных инстанциях.
Важно уточнять сроки выполнения анализа и наличие услуги выезда специалиста для забора пробы, чтобы избежать ошибок при транспортировке и хранении образцов. Удобство расположения и прозрачность прайс-листа помогут сэкономить время и средства.
Нужно ли заранее записываться и какие документы требуются
В большинстве лабораторий Москвы предварительная запись обязательна. Это связано с ограниченным количеством мест и необходимостью подготовить материалы для анализа. Записаться можно по телефону или через официальный сайт лаборатории. При визите важно уточнить, какие виды анализов вы планируете сдавать – для разных тестов могут быть разные требования.
Для сдачи воды обычно достаточно предъявить паспорт или иной документ, удостоверяющий личность. Если анализ проводят по заказу юридического лица, потребуется доверенность и копия учредительных документов. В некоторых случаях могут попросить заполнить специальную анкету с информацией о пробе и месте отбора.
Образец воды необходимо правильно упаковать в стерильную тару, которую чаще всего выдают в лаборатории при записи или по предварительной договорённости. При самостоятельном сборе важно соблюдать инструкции по объёму и хранению, чтобы результат был достоверным.
Как правильно отобрать пробу воды для лабораторного анализа

Для достоверного результата важно соблюдать точный порядок действий при заборе воды.
- Используйте стерильную тару, выданную лабораторией, или тщательно промытую и прокипячённую стеклянную или пластиковую бутылку объёмом 0,5–1 литр.
- Перед отбором промойте кран в течение 2–3 минут, чтобы смыть застоявшуюся воду и частицы.
- Набирайте воду в тару, не прикасаясь внутрь крышки и горлышка, чтобы избежать загрязнения.
- Заполняйте ёмкость полностью, оставляя минимум воздуха, особенно при анализе на микробиологические показатели.
- Если анализируют холодную воду, набирайте её в естественной температуре; для горячей воды – дайте воде остыть до 40 °C, если лаборатория не указала иное.
- Плотно закройте крышку, избегая попадания загрязнений на резьбу и внутреннюю поверхность.
- Подпишите пробу, указав дату, время забора и точное место отбора (например, конкретный кран или источник).
- Доставьте пробу в лабораторию в течение 2 часов, при невозможности – храните в прохладном месте не более 24 часов.
Для некоторых видов анализов (например, химического состава) могут потребоваться дополнительные условия хранения и транспортировки – уточняйте в лаборатории заранее.
Можно ли вызвать специалиста для отбора воды на дом

В Москве большинство лабораторий, принимающих воду на анализ, предлагают услугу вызова специалиста для отбора проб на месте. Это позволяет получить точный образец с минимальным риском его загрязнения или изменения свойств.
Для вызова специалиста достаточно связаться с лабораторией по телефону или через сайт, указав адрес и цель анализа. В зависимости от района Москвы, выезд обычно осуществляется в течение 1–3 рабочих дней.
Стоимость услуги колеблется от 1500 до 4000 рублей, в зависимости от сложности забора и вида анализа. Некоторые лаборатории включают выезд специалиста в стоимость полного пакета исследований.
При выезде сотрудник приносит стерильную тару и инструменты, выполняет отбор согласно ГОСТ или санитарным нормам, фиксирует параметры и оформляет необходимые документы для дальнейшего исследования.
Для оптимальных результатов рекомендуется согласовать с лабораторией требования к предварительной подготовке источника воды (например, промывка крана, время сброса воды).
Услуга вызова специалиста особенно актуальна для анализа скважинной, колодезной или технической воды, где самостоятельный забор может привести к искажению результатов.
Сколько времени занимает получение результатов анализа воды

Сроки зависят от типа анализа и лаборатории. Стандартный химический анализ занимает от 3 до 7 рабочих дней. Микробиологическое исследование обычно проводится в течение 5–10 дней, так как требует выращивания культур бактерий.
Для экспресс-анализа некоторых показателей, например, уровня жесткости или pH, результат можно получить за 1–2 дня, но такие услуги доступны не во всех лабораториях.
Перед сдачей образца уточните у выбранной лаборатории конкретные сроки, поскольку в период повышенного спроса ожидание может увеличиваться на несколько дней. В некоторых случаях возможна услуга ускоренного анализа с доплатой.
Результаты выдаются в бумажном виде или по электронной почте. Обязательно уточните формат получения, чтобы заранее подготовиться к последующим действиям по улучшению качества воды.
Что делать, если результаты анализа воды показали превышения

При обнаружении в воде показателей, выходящих за допустимые нормы, необходимо сразу ограничить её использование для питья и приготовления пищи. Сначала уточните, какие именно параметры превышены: микробиологические показатели, химические вещества или тяжёлые металлы.
Если превышены микробиологические показатели (например, общее микробное число, кишечная палочка), рекомендуется провести повторный анализ из другой точки водоснабжения, чтобы исключить локальное загрязнение. До получения новых данных используйте фильтры с обеззараживанием ультрафиолетом или кипятите воду минимум 5 минут.
При выявлении химических загрязнителей, таких как нитраты, хлориды, железо или тяжёлые металлы (свинец, ртуть, кадмий), необходимо обратиться в местные службы водоканала или санитарно-эпидемиологическую станцию с результатами анализа. Возможно, потребуется провести комплексное обследование источника водоснабжения.
Для временного решения проблемы стоит использовать бутилированную воду или установить в доме системы обратного осмоса или сорбционные фильтры, рассчитанные на конкретные виды загрязнителей.
Если вода из скважины или колодца, проведите дополнительную очистку и дезинфекцию скважины, включая промывку и обработку специализированными реагентами. Регулярно повторяйте анализ воды для контроля качества.
При систематических превышениях обратитесь к специалистам по качеству воды для разработки долгосрочного плана очистки и контроля. Игнорирование результатов анализа может привести к ухудшению здоровья, особенно у детей, пожилых и людей с хроническими заболеваниями.
Вопрос-ответ:
Где в Москве можно сдать воду для проверки на качество?
В Москве существует множество лабораторий, принимающих пробы воды на анализ. Обычно можно обратиться в государственные санитарно-эпидемиологические службы, частные лаборатории или специализированные центры экологического контроля. Для сдачи анализа нужно взять пробу воды в чистую тару и обратиться в выбранное учреждение, где проведут проверку по необходимым параметрам.
Какие виды исследований воды доступны в московских лабораториях?
В лабораториях Москвы можно проверить воду по разным показателям: микробиологические (наличие бактерий и вирусов), химические (содержание металлов, нитратов, пестицидов), физические (цвет, запах, мутность) и радиологические. Часто такие проверки требуются для питьевой воды, воды из скважин, колодцев или воды из системы водоснабжения.
Нужно ли записываться заранее, чтобы сдать воду на анализ в Москве?
В большинстве лабораторий Москвы рекомендуется предварительно записаться или связаться с ними по телефону. Это позволяет уточнить список необходимых документов, требования к упаковке пробы и сроки проведения исследований. Некоторые центры работают только по записи, чтобы организовать прием проб и обеспечить точность результатов.
Сколько времени занимает получение результатов анализа воды в Москве?
Сроки зависят от типа анализа и загруженности лаборатории. В среднем, базовые исследования воды занимают от 2 до 5 рабочих дней. Если требуется более сложное исследование, например, на наличие тяжелых металлов или радионуклидов, время может увеличиваться до 7–10 дней. По окончании проверки результаты обычно выдаются в письменном виде с подробным описанием.
